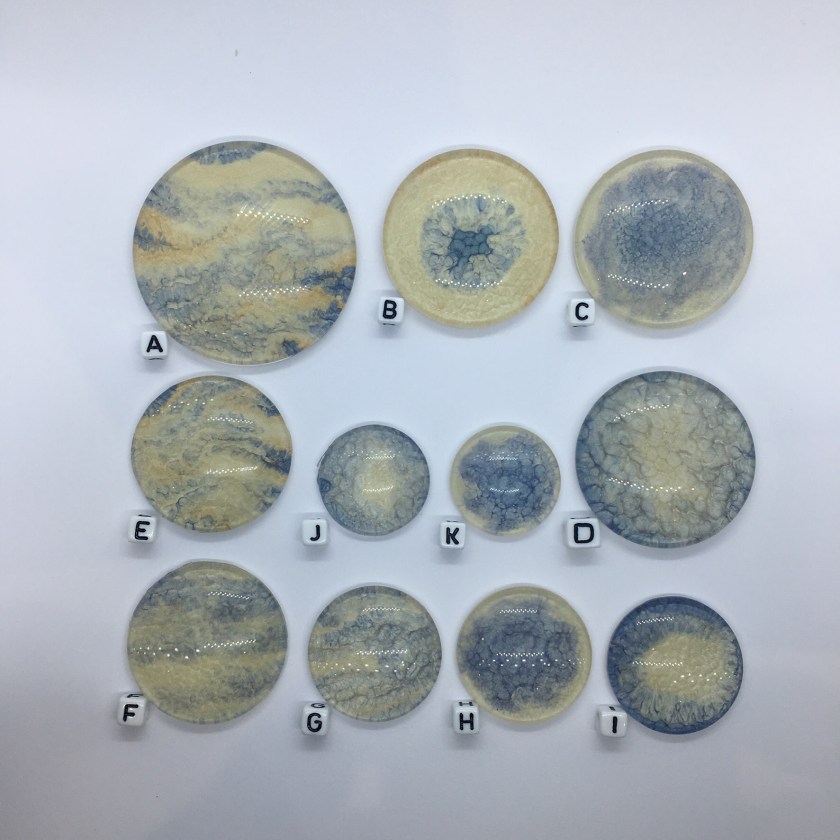

This year for the Stitch n Craft challenge the theme was ‘Anything Goes’ – so no theme, no packs, no requirements, just enter something you’ve worked on this year that you’re proud of. So I beaded away at a particular thread of an idea, and was getting really pleased with it when I realised it didn’t really meet a key requirement to use some beads bought from them. Yes the core of the work used their beads, but the flashy bits, the visible bits were all from elsewhere. So this didn’t really feel to me like it was entering into the spirit of the competition, so although I ‘d already paid the entry fee I decided to pause for a little think.
Whilst I was thinking (OK procrastinating) the theme was announced for another competition that fit my nearly complete piece perfectly. In every other way that competition seemed like a better fit for it, so I decided to enter something else at Stitch and Craft instead – another one of my big bead embroidered necklaces perhaps, using beads that were definitely from them and some of my own cabochons?
Digging around I found a set of experimental cabs that I made in the early days using the left over paint mess from a salad spinner painting session with the boys. Surreal but true. The drips and dribbles gave an acrylic pour effect, and I’d even tried mopping up the excess paint from the side of the spinner by blotting, giving a lovely blotchy effect which I’d then used to make a huge 50mm cab.
The large cab made me think of Monet’s waterlily paintings, particularly those in the Orangery in Paris, where if you stand close the beautiful paints form gorgeous abstract patterns. In turn that made me think of water, with silvery bubbles and that got me to my base colour scheme of silver, etched vitrail and metallic mint green (Miyuki 4214 and 4214F), and I started my usual process of pulling out a big range of beads to kick start the design process. A stash search unearthed some vitrail ridged back cabs from The Old Bicycle Shop, and a wonderful crumple backed oval Crystal Electra geode cabochon from Stitch n Craft themselves. The colours though were still a bit subtle, and I needed to call on more of the contrasting colours in the cabs and crystals, so I added some pink – not my usual fuchsia though, but a more subtle Swarovski Crsytal Peony Pink (again from Stitch N Craft). And finally I spent some of my Beadworker’s Guild Founder’s Award prize money on some gorgeous Anna Bronze findings, this time in an antique silver finish, but repeating some of the organic shapes I’d used in that piece. Then I got stuck in, using what is becoming a standard process for these type of pieces.

First I did a rough layout and photographed it, then rather than bezelling onto a single backing I bezelled each of the flat backed hand made cabs onto a separate piece of backing. I do this because I find that adding the bezel changes the shape, size and overall appearance of the cab, and usually means I want to alter the layout significantly (usually to add more space). I used a simple backstitch/peyote bezel – quick and secure, adding a picot to some but not all. If you want to learn how to do a basic back stitch/peyote bezel then take a look at my SunStar tutorial which takes you through this technique.

Then I did the beadwoven bezels for the crystals and other cabochons – biggest first, then using a variant of whatever bezel I came up with for that one (with less repeats, or smaller beads) on the smaller ones to give a sense of continuity, and a repeat of the method I used on my Great Dixter necklace for the chatons.
Then I looked at layout again, adding the metal pieces, and did my trick of deciding on a shape based on a specific neckline – in this case I’m really glad because the original layouts had been for quite a shallow ‘v’ which wouldn’t have been great in wear. Then I was ready to start attaching the bead embroidered cabs to a fresh base, using both glue and stitching (these are big cabs so it’ important to be secure, particularly if there is any flex in the finished piece as this could break the glue bond on bending).
Then I checked the layout yet again, working out how I would attach the bead woven cabochons (which sit up above the base and bead embroidered cabs, and where and how to attach the metal pieces. This showed me what space to leave free, and where I needed to cover the base with bead embroidery – which I then did using simple stack stitch, and supplemented with some lovely Backlit Spectrum and Etched Vitrail 2 hole cab beads (in my head these were the bubbles in the water). Next the attachment points for the straps (I didn’t complete the whole strap, as I wanted to check the length with the finished centrepiece, but I chose the beads, got it started and reinforced it repeatedly), and then finally I was able to secure the metal pieces and crystals.

At this point it was becoming apparent that the 50mm cabochon was pretty heavy. Inevitably the bead backing is weakened as well when you stitch into it, so it was time for some serious reinforcement, sandwiching, glueing and stitching on additional sheets of backing, and even some flexible plastic cocktail sticks.

Of course those are hidden by the beading above, and the ultrasuede behind, so once that was on I worked on the edging, adding a picot to the focal cab and a simple sunshine edge to the remainder.

The neck strap of backlit 2 hole cabs was completed with simple loop and a vitrail Czech button from Snoochy, and then the whole thing was posted off to Dorset.

You can see all of the entries here on the Stitch n Craft website – in the end I was beaten on the day by Chloe Menage’s gorgeous bead embroidered headpiece, which she’d made for her own wedding. However that’s not really why I enter competitions – it’s to stretch and challenge myself to do something original and ‘me’, and I’m still really very pleased with this piece. It’s the third I’ve made using this process (the first was my ‘Diva’, the second ‘Great Dixter), and each time it gets a bit easier, and a bit more enjoyable. It was the last Stitch N Craft Beady picnic (and probably the last challenge) as they’re closing the studio to focus on mail order only, so as I’ve enjoyed them so much over the years I was really glad to be able to enter again this year, and I’ve got a lovely necklace to show for it too.